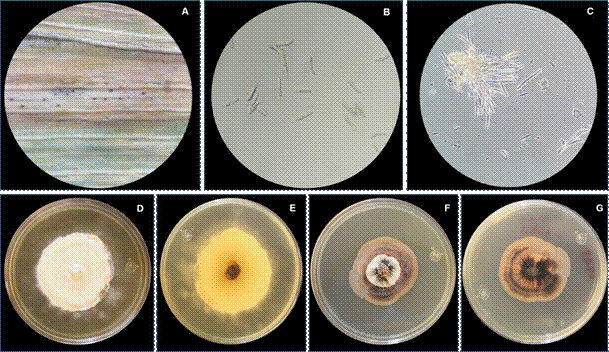
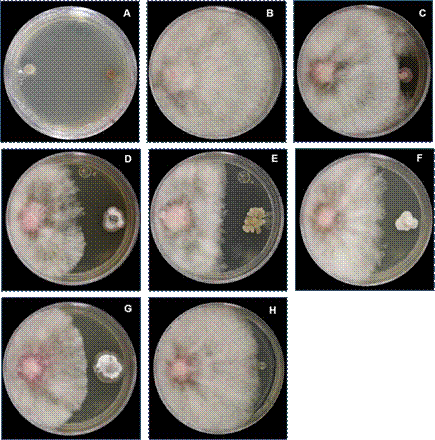
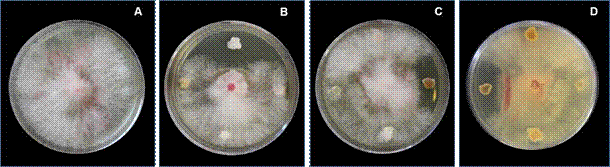

Introducción
La producción agrícola se ve obligada a acelerar e incrementar sus rendimientos para abastecer la demanda de alimentos de acuerdo al crecimiento poblacional, en el 2022 se registraron 8,000 millones de personas y se prevén que sean 8,500 millones en 2030 (ONU, 2022).
Los cereales forman parte de la base de alimentación humana (FAO, 2001); Sinaloa, México, es el principal productor de cereales, especialmente de maíz (SADER, 2022) y su sistema productivo es intensivo en agroquímicos (Cruz y Leos, 2018). Los problemas fitosanitarios como las manchas foliares representan un daño en el funcionamiento de las plantas y se refleja en la pérdida de rendimiento de 4 y hasta 38 % en regiones productoras (Mariscal-Amaro et al., 2017), lo que requiere de estrategias de manejo eficientes, sustentables y rentables para cumplir con los rendimientos esperados por la población. Los principales hongos causantes de manchas foliares o tizones son del género Bipolaris, Fusarium, Alternaria (Prescott et al., 1986); sin embargo, aún hay agentes causales desconocidos (Mariscal-Amaro et al., 2017). En México se han reportado a F. graminearum, F. avenaceum, F. equisetii, F. proliferatum, F. subglutinans, F. oxysporum, F. thapsinum y F. andiyazi como las especies asociadas también a pudrición de diferentes órganos (Gilchrist-Saavedra et al., 2005; Leyva-Mir et al., 2017; Rangel- Castillo et al., 2017).
Cabe mencionar que se considera el mejoramiento genético, dosis de fertilización, control biológico y químico como tecnologías para generar resistencia a enfermedades y la capacitación en los diferentes segmentos de la cadena productiva como una estrategia para aumentar la productividad de los cultivos (Cerutti, 2019; SENASICA, 2021; SADER, 2023). En el caso de los plaguicidas representa un problema mundial en el sector salud y ambiental, por la residualidad de compuestos en los alimentos, contaminación del suelo y agua (Rodríguez-Eugenio et al., 2018; OMS, 2022), ya que la contaminación puede ocurrir por bioacumulación, transporte, precipitación pluvial, evaporación, escurrimientos, infiltraciones y lixiviaciones (Jáquez-Matas et al., 2022). La Organización Mundial de la Salud (OMS) se encarga de examinar pruebas y elaborar listas de los límites máximos de residuos aprobados internacionalmente; no obstante, países en vías de desarrollo necesitan alternativas de bajo impacto ambiental y desarrollar tecnología rentable, para incrementar su uso o sustituir a los plaguicidas conocidos y poco costosos, que han sido prohibidos en países desarrollados, pero siguen siendo usados en países como México (OMS, 2022).
Una alternativa viable son las actinobacterias, un tipo de bacterias Gram positivas, variables en cuanto a su necesidad de oxígeno (Álvarez et al., 2017) que contienen propiedades antagónicas y con potencial inhibitorio de crecimiento de hongos fitopatógenos de importancia agrícola, debido a la segregación de metabolitos secundarios como: enzimas hidrolíticas, quitinasas, xilanasas y celulasas; degradadoras de la pared celular de patógenos, antibióticos (estreptomicina y kanamicina), antifúngicos y pigmentos (Evangelista et al., 2017; Parada et al. 2017; Quiñones et al., 2014; Cabrera et al., 2020).
Los géneros de actinobacterias identificados con mayor frecuencia son Streptomyces, Micromonospora, Rhodococcus, Salinispora, Frankia, Corynebacteriaum, Mycobacterium, Nocardia y Bifidobacterium (Barka et al., 2016). El efecto inhibidor de actinobacterias obtenidas de muestras de suelo se han observado en diferentes escenarios.
En Nuevo León se registró el efecto inhibitorio sobre Phytophthora capsici, Rhizoctonia solani y Macrophomina phaseolina con un rango en la variable del efecto inhibidor del 60 al 100 % (Rodríguez-Villareal et al., 2014). Mientras que en Guanajuato lograron identificar 82 cepas, de las cuales, tres presentaron un efecto inhibitorio sobre R. solani,
P. capsici y F. oxysporum, con un porcentaje de inhibición radial promedio de 81.8 % (Sánchez-García et al., 2019). En Hidalgo, se identificó la cepa Amycolatopsis BX17 con capacidad de inhibir el 100 % de crecimiento micelial de F. graminearum debido a la secreción de moléculas con actividad antifúngica (Cabrera et al., 2020). Finalmente, en Jalisco se detectaron al menos 49 cepas con un porcentaje de inhibición mayor del 50 %, como agentes antagónicos para Fusarium spp. en condiciones in vitro (Quiñones et al., 2014).
El antagonismo de las actinobacterias responde a una alta especificidad, aunque las especies que funcionan como antagónicos en un cultivo vegetal, pueden ser patogénicas para otros (Emmert y Handelsman, 1999; Glick, 1995). Por ello el objetivo de este trabajo de investigación fue detectar morfotipos de actinobacterias con potencial inhibitorio a hongos asociados con manchas foliares de trigo, sin perder de vista que Fusarium tiene una gran diversidad de especies causantes de síntomas de pudrición de raíz, atizonamiento en hojas, y espigas provocando pérdidas de hasta del 50 % (Ackermann y Pereyra, 2010).
Materiales y Métodos
Obtención de muestras
Se visitaron parcelas comerciales de trigo en etapa de llenado de grano (antesis a madurez fisiológica) en 136 localidades ubicadas en los Valles Altos de México, cada muestra fue compuesta por cuatro hojas con síntomas de atizonamiento y manchas. Fueron 25 localidades visitadas en Hidalgo, 45 en Estado de México, una en Morelos, cinco en Oaxaca, 15 en Puebla y 45 en Tlaxcala. Las muestras se trasladaron para su procesamiento en las instalaciones del Laboratorio de Fitopatología INIFAP- CEVAMEX, ubicado en el municipio de Texcoco de Mora, Estado de México.
Aislamiento de hongos
Se observaron 136 muestras de hojas con microscopio estereoscópico (marca LEICA Modelo EZ4D, fabricado en Heerbrugg, Switzerland), posteriormente se seleccionaron segmentos de 2 cm de hoja con síntomas y se desinfestaron mediante tres lavados (hipoclorito de sodio al 1 %, alcohol al 70 % y agua estéril) por un minuto. Los segmentos de hoja se colocaron bajo condiciones de cámara húmeda durante 48 h, con revisión cada 24 h. La masa de conidios que se desarrollaron en la superficie de las hojas, se colocaron en tubos de ensayo estériles de 10 mL con 1 mL de agua estéril, sometido a agitación en un vórtex para homogeneizar la solución, se dispersaron 20 µL con una micropipeta en cajas Petri con medio de cultivo papa dextrosa agar (PDA), 24 h después se revisaron los conidios germinados mediante el uso de microscopio óptico (marca LEICA Modelo EZ DM500, fabricado en Heerbrugg, Switzerland). Cada conidio germinado se transfirió a una nueva caja de Petri PDA (técnica modificada de Morales-Rodríguez et al., 2007).
Las colonias obtenidas se identificaron utilizando diferentes medios de cultivo como PDA (morfología y color de la colonia), APZ (Agar Papa Zanahoria, para incrementar la colonia) y SNA (Agar Spezieller Nährstoffarmer, funciona para la producción de clamidiosporas, microconidios y macroconidios). La morfología se determinó siguiendo
las claves de Leslie y Sumerell (2006) y la guía de identificación de enfermedades comunes de los cereales de grano pequeño de Zillinsky (1984). La morfometría fue descrita de 100 estructuras (conidios, fiálides, macroconidios, conidióforos, etc.), para agrupar a los hongos por aislamientos.
Aislamiento de Actinobacterias
El aislamiento se realizó a partir de dos muestras compuestas de suelo provenientes del municipio de Bustamante, Nuevo León: M1B (67 morfotipos) compuesto por seis submuestras y M2B (77) compuestos por cinco submuestras, ambas tomadas de la rizósfera de árboles de aguacate; obtenidas y purificadas en el Campo Experimental General Terán, Montemorelos, N.L. (INIFAP). La técnica de aislamiento fue por medio de diluciones (10 -2 y 10 -3) en agua estéril y dispersión de 50 µL del mismo en medio de cultivo de agar nutritivo, posterior a las 24 y 72 h de la siembra se observaron en microscopio compuesto para realizar la trasferencia de microcolonias a nuevas cajas Petri con medio de agar nutritivo. Por las características morfológicas de las colonias aisladas se determinó que los organismos pertenecían al grupo de las actinobacterias.
Experimentos
Se establecieron dos bioensayos preliminares para detectar actinobacterias con mayor potencial de inhibición (> 20 %) la primera con 144 morfotipos distribuidos en 36 cajas Petri más una caja del testigo, en el segundo ensayo se utilizaron 16 morfotipos distribuidos en cuatro cajas Petri, más una caja del testigo; posteriormente se llevó a cabo una prueba de confrontación dual entre siete morfotipos de actinobacterias y tres hongos seleccionados previamente distribuidos en 63 cajas Petri más tres cajas de testigos. La variable utilizada para todas las pruebas fue el porcentaje de inhibición del crecimiento micelial (PICM) se calculó de acuerdo a la fórmula de Salazar et al. (2001), PICM = [(Crecimiento micelial del testigo - Crecimiento micelial con tratamiento) / Crecimiento micelial del testigo]*100. El crecimiento micelial se consideró como la medición en mm del crecimiento radial de la colonia del hongo que se desarrolló entre el disco de inóculo fungoso y el disco de la actinobacteria correspondiente.
Bioensayos preliminares. En cajas Petri de 65 x 15 mm, se colocó al centro un disco de inóculo (cuyo criterio de selección fue el hongo asociado más frecuente que se reportó en las muestras) y cuatro diferentes discos de morfotipos de actinobacterias en puntos extremos de una misma caja (sin repeticiones), adicionalmente en otra unidad se sembró un testigo en el cual solo se colocó en el centro el disco de inóculo. La distancia entre el hongo y el disco del actinomiceto fue de 1.5 cm. El registro de los datos de crecimiento micelial se realizó hasta que el testigo cubrió en un 100 % el área de la caja Petri.
Confrontación dual. Esta prueba se realizó únicamente con las actinobacterias que mostraron un mayor porcentaje de inhibición en el bioensayo preliminar (> 40 %). Cada una de las actinobacterias se confrontó con tres aislamientos fungosos, dos aislados de las muestras de trigo y un tercero, Fusarium aislamiento 3 (Fusarium proliferatum), el cuál fue donado de la colección personal de la Dra. Leticia Robles y que fue utilizado considerando que la especie es de importancia agrícola en trigo por estar asociado al amarillamiento o madurez prematura del trigo (Rangel-Castillo et al., 2017). La disposición de los discos de la actinobacteria y del hongo se ubicaron en los extremos de
la caja Petri, con una separación entre sí de 3 cm. La velocidad de crecimiento del hongo durante los bioensayos fue rápida, por lo que se decidió diferir el día de la transferencia, primero se sembró el disco del inóculo de la actinobacteria y a los dos días el disco del hongo, simulando que la aplicación del tratamiento fuese preventiva.
Resultados
Identificación de hongos asociados al tizón y manchas foliares del trigo
Se identificaron siete hongos de los cuales tres se asocian al atizonimiento de hoja en trigo (del género Alternaria, Bipolaris y Fusarium) el cual consiste en la presencia de halos cloróticos que se extienden a lo largo de la hoja; dos tipos de royas (ambos del género Puccinia), las cuales no fueron parte del experimento por ser parásitos obligados; y dos hongos asociados a manchas foliares también conocidas como septoriosis (Septoria y Zymoseptoria).
Género Alternaria. Fue identificado por la presencia de conidios característicos del género, Mata-Santoyo et al. (2018) indican que Alternaria se asocia a Bipolaris sorokiniana como potenciador del daño o lo identifican como un hongo saprófito en aislamientos obtenidos de muestras de trigo. No obstante, Perelló et al. (2015) menciona que especies de Alternaria han provocado la pérdida del rendimiento del 60 % en condiciones favorables, siendo identificadas como patógeno de enfermedades foliares y en el grano de trigo.
Los conidios tuvieron un grosor aproximado de 3-6 µm y longitudinalmente midieron 19-46.07 x 7.56-14.22 µm. Las colonias de Alternaria spp. son de coloración verde obscuro en etapa madura, mientras que en pleno crecimiento presenta tonalidades blanquecinas y grisáseas, de forma circular, de superficie plana pero algodonosa y con bordes filamentosos (Figura 1).
Género Bipolaris. Los síntomas observados fueron lesiones necróticas de color café obscuro a lo largo de las hojas (Figura 2A), en condiciones de cámara húmeda se detectó la formación de conidióforos en la parte superficial de la hoja, al igual que micelio obscuro y denso. Los conidios y conidióforos permiten una identificación del género Bipolaris (antes Helminthosporium) (Mata-Santoyo et al., 2018), los conidios observados fueron oblongos de color café oliva, septados ligeramente curvos, con paredes lisas y una cicatriz basal prominente (Figura 2B). Los conidios midieron aproximadamente de 34-
63.12 x 10.06-18-5 µm, por lo que presentaron de tres a nueve septas por conidio. Los conidióforos se desarrollaron individualmente con un tamaño promedio de 118.5 - 152 x 6.4-8.2 µm. Las colonias fueron de coloración verde obscuro, de forma granular algodonoso, con elevación umbilicada y bordes lobulados (Figura 2C y D).

Figura 1 Colonias de Alternaria spp. A) Colonia en medio de cultivo PDA. B) Colonia en medio de cultivo APZ. C) Crecimiento micelial en etapa temprana en medio de cultivo PDA. D) Colonia en medio PDA con presencia de uno o dos anillos concéntricos observados a contra luz. E) Colonia en medio PZA con presencia de varios anillos concéntricos observados a contra luz. F-I) Conidios y cadena de conidios.

Figura 2 Síntomas y colonias de Bipolaris sp. A) Síntoma de Bipolaris sp., atizonamiento a lo largo de la hoja de trigo. B) Conidio con tres septos ligeramente marcados (a. cicatriz basal), conidióforos (b) y micelio (c). C) Colonia en medio de cultivo PDA. D) Reverso de la placa Petri en medio de cultivo PDA.
Género Fusarium. El síntoma que se observó fue una mancha clorótica con el centro blanquecino (Figura 3); aunque hay registros de que en estados tempranos de desarrollo las manchas son de color verde grisáceo y en estados más avanzados las manchas se tornan ovaladas de color café grisáceo (Zillinksy, 1984). No obstante, la masa de conidios de los que se logró hacer el aislamiento de Fusarium, se obtuvo de hojas considerablemente secas.
Por la morfología de las estructuras se logró identificar el género por la presencia de macroconidios, microconidios, clamidosporas y tipo de fiálides. La morfología sugirió dos tipos de aislados de Fusarium spp. En medio de cultivo PDA la primera colonia presentó coloración amarilla a rojiza, el crecimiento fue circular, superficie plana pero algodonosa y bordes filamentosos lo cual es similar con la descripción de F. graminearum (Leyva-Mir et al., 2017) (Figura 3); sin embargo, para referencias posteriores se hablará de Fusarium aislamiento 1. Los macroconidios recuperados del medio de cultivo SNA midieron de 21.01-63.14 x 3.08-4.85 µm y las clamidosporas de 7.37 - 16.52 µm (Figura 3).
La segunda colonia en medio de cultivo PDA fue de color blanquecina, de crecimiento circular, ligeramente anillada, superficialmente algodonosa y plana (para futuras referencias se hablará de esta cepa como aislamiento 2) (Figura 3). El tamaño de los microconidios fue de 5.55-11.2 x 1.73-3.79 µm, y clamidosporas (Figura 3).

Figura 3 Características de Fusarium spp. A y E) Vista frontal y reverso de la colonia en medio de cultivo PDA de Fusarium aislamiento 1. B y F) Vista frontal y reverso de la colonia en medio de cultivo SNA de Fusarium aislamiento 1. C y G) Vista frontal y reverso de la colonia en medio de cultivo PDA de Fusarium aislamiento 2. D y H) Vista frontal y reverso de la colonia en medio de cultivo SNA de Fusarium aislamiento 2. I) Macroconidio de Fusarium aislamiento 1. J) Microconidios de Fusarium aislamiento 2. K) Clamidiosporas de Fusarium aislamiento 2. L) Microconidios y fiálides (a) aislamiento 2.
Género Puccinia. Las especies del género Puccinia se conocen como agentes causales de las royas, considerados como “los grupos de microorganismos fitopatógenos más diversos y con mayor importancia económica mundial en la producción agrícola y forestal” (Zuluaga et al., 2008). El síntoma corresponde a la presencia de pústulas que pueden contener dos tipos de esporas, urediosporas y teliosporas. Puccinia 1, se observó con uredias de color rojo anaranjado, esféricas y sin ornamentaciones con un diámetro de 22.53-28 µm. Por otro lado, Puccinia 2, se observó que la distribución de las uredias en las hojas de trigo era lineal. La morfología de las uredias fue de color amarillo, ligeramente esféricas y de 27.3-32.05 µm de diámetro (Figura 4).
Géneros Septoria y Zymoseptoria. Durante el muestreo se encontraron diversos grados de severidad de la septoriosis, los síntomas: halos cloróticos y dentro de ellos, picnidios distribuidos en todo el halo (Figura 5).

Figura 4 Pústulas de roya. A) Pústulas de roya en hoja de trigo. B) Urediospora de Puccinia 1. C) Urediospora de Puccinia. D) Teliospora de Puccinia 1. E) Teliospora de Puccinia 2.
Figura 5 A) Halos cloróticos con picnidios. B) Conidios de Septoria sp. C) Conidios de Zymoseptoria sp. observado en fase de contraste. D) Vista frontal de la colonia Septoria sp. en PDA. E) Reverso de la colonia Septoria sp. en PDA. F) Vista frontal de la colonia de Zymoseptoria sp. en PDA. G) Reverso de la colonia Zymoseptoria sp.
La presencia de Septoria y Zymoseptoria en ocasiones puede ser diferenciada en el miscroscopio estereoscópico por una ligera diferencia en el color del picnidio, siendo Zymoseptoria de color negro a un tono grisáceo y Septoria con color negro a café obscuro.
La forma de la colonia de Septoria es ligeramente circular con algunas irregularidades, su superficie es ligeramente convexa y sus orillas ligeramente filamentosas. Los conidios son del tipo didimospora corta y recta, sin ornamentaciones, con color amarillo pálido. El tamaño de los conidios fue de aproximadamente 14.6- 20.2 x 2.86-3.48 µm.
En el caso de Zymoseptoria la colonia fue ligeramente circular con algunas irregularidades, su superficie es lisa y con elevación umbeliforme (Figura 6). Cabe mencionar que la colonia de Zymoseptoria se desarrolló de dos formas, la primera en estadíos tempranos con una consistencia semi-líquida o viscosa de color rosado, y la segunda, cuando la colonia maduró desarrolló micelio de color negro con segmentos blanquecinos. Por otro lado, los conidios fueron filiformes, sin ornamentación, hialinos, ligeramente curvado el tamaño fue de 40-77.3 x 1.6-2.84 µm (Figura 5).
Incidencia de enfermedades
Una vez identificados los principales hongos presentes en las muestras de trigo, se obtuvo la incidencia de acuerdo al estado en que se recolectó (Cuadro 1).
Cuadro 1 Porcentaje de incidencia de hongos asociados a enfermedades en cultivo de trigo muestreados en principales estados productores.
| Estado | Porcentaje de incidencia por género | |||
|---|---|---|---|---|
| Alternaria spp. | Bipolaris spp. | Fusarium spp. | Puccinia spp. | |
| Hidalgo | 20.0 | 4.0 | 52.0 | 92.0 |
| México | 24.4 | 2.2 | 46.7 | 86.7 |
| Morelos | 0.0 | 0.0 | 0.0 | 100.0 |
| Oaxaca | 20.0 | 0.0 | 20.0 | 80.0 |
| Puebla | 13.3 | 0.0 | 60.0 | 80.0 |
| Tlaxcala | 8.9 | 0.0 | 35.6 | 88.9 |
| Promedio | 14.4 | 1.0 | 35.7 | 87.9 |
Considerando la incidencia de los hongos en las muestras evaluadas se encontró que Puccinia y Fusarium, fueron los más frecuentes con 87.9 y 35.7 %, respectivamente. Por lo anterior, se seleccionó a Fusarium para las pruebas in vitro. Los géneros de Septoria y Zymoseptoria no se pudieron confirmar en todos los casos en que se observaron síntomas, por lo cual no se consideró en la incidencia.
Obtención de Actinobacterias y Bioensayos preliminares
De las muestras de suelo analizadas M1B (67) y M2B (77) se aislaron 144 actinobacterias del municipio de Bustamante, Nuevo León. Las actinobacterias con mayor porcentaje de inhibición micelial (42.9 %), corresponden a 17/144 morfotipos, es decir, sólo el 11.1 % de la población evaluada. El resto, no presentó ningún efecto inhibitorio. Los morfotipos seleccionados fueron, de acuerdo a su grupo M1B: M1, M4, M12, M14, M 16, M33, M41, M55, M57, M60; y los del grupo M2B: M3, M15, M27,
M45, M70, M73 y M74. En el segundo bioensayo, los morfotipos presentaron una variación en los resultados en comparación con la primera, específicamente el segundo grupo fue el que presentó una disminución de 25.1 % en la inhibición del crecimiento micelial (Cuadro 2).
Cuadro 2 Porcentaje de inhibición de crecimiento micelial (PICM) de bioensayos preliminares de morfotipos de actinobacterias en contra de Fusarium aislamiento 1.
| Grupo | Primer bioensayo | Segundo bioensayo | ||||
|---|---|---|---|---|---|---|
| Morfotipo | PICM (%) | Promedio | Morfotipo | PICM (%) | Promedio | |
| 1 | 45.5 | 1 | 47.4 | |||
| 4 | 40.9 | 4 | 63.2 | |||
| 12 | 40.9 | 12 | 52.6 | |||
| 14 | 40.9 | 14 | 36.8 | |||
| M1B | 16 | 36.4 | 40.4 | 16 | 47.4 | 40.9 |
| 33 | 40.9 | 33 | 57.9 | |||
| 41 | 50.0 | 41 | 57.9 | |||
| 55 | 36.4 | 55 | 21.1 | |||
| 57 | 31.8 | 57 | -15.8 | |||
| 3 | 50.0 | 3 | -5.3 | |||
| 15 | 50.0 | 15 | 5.3 | |||
| 27 | 31.8 | 27 | -5.3 | |||
| M2B | 45 | 54.5 | 45.4 | 45 | 36.8 | 20.3 |
| 70 | 31.8 | 70 | 21.1 | |||
| 73 | 40.9 | 73 | 21.1 | |||
| 74 | 59.1 | 74 | 68.4 | |||
Las actinobacterias seleccionadas de los bioensayos preliminares fueron MIB M4, MIB M33, MIB M41, M2B M60 y M2B M74, mismas que presentaron un PICM mayor de 40 %, comprobando que algunas actinobacterias afectan el crecimiento micelial de Fusarium morfotipo 1 a los dos días de la siembra (Figura 6).
Bioensayo de confrontación dual y tasa de crecimiento
Si bien se destaca la capacidad de inhibición de algunos aislamientos, también se observa mayor grado de especificidad, considerando que hay diferentes rangos en el PICM de acuerdo a su exposición al hongo de Fusarium. Sobresalen estadísticamente tres morfotipos M1B M4, M1B M33 y M2B60 con los mayores porcentajes de inhibición; no obstante, cada uno tuvo mayor efectividad con uno de los aislados evaluados. M1B M4 tuvo mayor efectividad con Fusarium aislamiento 3, M1B33 con Fusarium aislamiento 2 y M2B M60 con Fusarium aislamiento 1 (Cuadro 3 y Figura 7).
Cuadro 3 Porcentaje de inhibición del crecimiento micelial (PICM) de tres aislamientos del género Fusarium de trigo y confrontadas con siete morfotipos de actinobacterias.
| PICM por aislamiento de Fusarium | |||||||
|---|---|---|---|---|---|---|---|
| Grupo | Morfotipo | Fusarium aislamiento 1 | Fusarium aislamiento 2 | Fusarium aislamiento 3 | |||
| M1 | 8.0 | e | 6.2 | e | 8.8 | d | |
| M4 | 43.8 | b c | 42.5 | a b | 66.9 | a | |
| M1B | M16 | 17.2 | d | 11.4 | d | 4.9 | e |
| M33 | 48.8 | a b | 47.1 | a | 47.9 | b | |
| M41 | 38.3 | c | 31.3 | c | 43.4 | b | |
| M2B | M60 | 59.8 | a | 29.1 | c | 59.8 | a |
| M74 | 18.8 | d | 16.3 | d | 23.0 | c | |
zMedias con letras iguales no son estadísticamente diferentes (Tukey, P ≤ 0.05).
Figura 7 Confrontación dual con Fusarium aislamiento 1. A) Distribución de los discos de Fusarium. B) Crecimiento de la colonia testigo de Fusarium aislamiento 1. C) Fusarium aislamiento 1 y morfotipo M1BM1. D) Fusarium aislamiento 1 y morfotipo M1B4. G) Fusarium aislamiento 1 y morfotipo M2B60. H) Fusarium aislamiento 1 y morfotipo M2B74. I). Crecimiento micelial de testigo Fusarium aislamiento 1.
En el Cuadro 4, se puede observar que Fusarium aislamiento 1 fue el que presentó mayor velocidad de crecimiento a partir del tercer día de establecido, por lo que la
diferencia de respuesta entre aislamientos de ese género estuvo en función de la velocidad de crecimiento del hongo.
Cuadro 4 Tasa de crecimiento de Fusarium aislados de hojas de trigo.
| Hongo | Tasa de crecimiento (cm día-1) | ||||||||
|---|---|---|---|---|---|---|---|---|---|
| Día 1 | Día 2 | Día 3 | Día 4 | Día 5 | Día 6 | Día 7 | Día 8 | Día 9 | |
| Fusarium aislamiento 1 | 0.3 | 0.30 | 0.95 | 0.95 | 0.74 | 0.39 | 0.37 | 100 | 0.3 |
| Fusarium aislamiento 2 | 0.51 | 0.52 | 0.53 | 0.44 | 0.39 | 0.33 | 0.28 | 0.29 | 0.28 |
| Fusarium aislamiento 3 | 0.36 | 0.38 | 0.66 | 0.7 | 0.487 | 0.512 | 0.462 | 0.162 | 0.115 |
Discusión
De acuerdo con Savary et al. (2019) la roya junto con el tizón de la espiga por Fusarium, manchas foliares y oídio han provocado la pérdida del rendimiento de trigo superiores al 1 % a nivel mundial, lo que podría representar la evolución y resistencia de los patógenos a las estrategias de manejo que se han aplicado a lo largo del tiempo.
En este estudio se encontró la presencia Puccinia spp. y Fusarium spp., principalmente; Alternaria spp., Bipolaris spp., Septoria spp. y Zymoseptoria spp., como hongos con menor frecuencia en la región de los Valles Altos, lo cual en general coincide con lo reportado por Mariscal-Amaro et al. (2017) quiénes mencionan a Bipolaris sorokiniana, Alternaria alternata, Septoria tritici, Fusarium equiseti, F. proliferatum, F. moniliforme, Curvularia spp. y Cladosporium spp., como hongos fitopatógenos presentes en hojas de trigo con alto potencial de causar síntomas de pudrición en raíz y tallo de la planta, así como, contaminar el grano y generar pudriciones en almacén también.
En 2021, el Servicio Nacional de Sanidad, Inocuidad y Calidad Agroalimentaria (SENASICA) por medio de la Dirección General de Sanidad Vegetal (DGSV), promovió una estrategia operativa para el manejo fitosanitario de trigo, para el caso de especies del género Puccinia y Fusarium se habla solo del control químico y únicamente como último recurso (SENASICA, 2021). Anteriormente recomendaban el uso de Trichoderma harzianum como control biológico del tipo preventivo en semilla; sin embargo, el manejo integral requiere de tratamientos aplicables no solo en semilla, sino también en plántula o en puntos críticos del desarrollo.
El uso de actinobacterias para el control de enfermedades, se ha explorado a nivel in vitro: la actinobacteria AAH5 aislada de muestras de suelo de Saltillo, Coahuila, mostraron efectos de inhibición en un 49.4 % contra Fusarium spp. (Dávila et al., 2013), lo cual coincide con lo obtenido con este trabajo de investigación, aunque también se logró destacar lo siguiente: 1) Es posible que exista un efecto potenciador entre actinobacterias cuando comparten un mismo espacio; 2) Existe especificidad entre el morfotipo de la actinobacteria y el aislamiento del hongo.
La especificidad, así como el posible efecto potenciador puede deberse al complejo proceso de señalización química entre organismos, como es el caso de bacterias fitopatógenas y las plantas. De acuerdo con Emmert y Hadelsman (1999) las actinobacterias poseen un alto grado de especificidad en relación a la capacidad de
enfermar o proteger a algunas plantas, es decir, las actinobacterias que son benéficas para algunas plantas, para otras puede ser causantes de enfermedades. Por otro lado Gudesblat (2007) menciona que las bacterias como parte de un proceso evolutivo, desarrollaron diferentes mecanismos para combatir las defensas naturales de la planta así como para detectar la presencia de bacterias congéneres con las que pueden colaborar para lograr la expresión de una infección, por lo que posiblemente las actinobacterias evaluadas en los bioensayos pudieron detectar la presencia de las otras actinobacterias (en la misma caja Petri) con las que tuvieron compatibilidad y potencializaron el efecto inhibidor de crecimiento en el hongo, pero al realizar la confrontación dual, la actinobacteria actúo por sí sola y el efector inhibidor fue menor. Lo anterior se observa en el caso del morfotipo M1B M1, donde tuvo un efecto de inhibición del 45.5 - 47.4 % en los bioensayos y en la confrontación dual (en la que se mantuvo la interacción entre la actinobacteria y el hongo) mantuvo un rango de 6.1 - 8.8 % de inhibición del crecimiento micelial. Otra posible razón, es la diferencia entre las distancias de los discos de la actinobacteria y los discos del hongo, como lo indica Rodríguez-Villareal et al. (2014) en el que sugiere que es un efecto de la concentración de compuestos no volátiles, pues existe una relación directa entre la cercanía de la colonia del actinomiceto y la concentración de compuestos, por lo que el hongo al estar más cerca de la actinobacteria en los bioensayos, estuvo en contacto de una concentración mayor de metabolitos secundarios (aunque no de la colonia de la actinobacteria) y se vio reflejado en el porcentaje de inhibición. Cabe mencionar que los metabolitos secundarios producidos por las actinobacterias son de vital importancia tanto para el mantenimiento de la especie como para la señalización y colonización de su hábitat (González et al., 2005). Sin embargo, además de los metabolitos secundarios, la competencia por el espacio y nutrientes también es un mecanismo de acción común en agentes de biocontrol frente a patógenos (Infante et al., 2008).
Conclusiones
Se identificaron tres morfotipos de actinobacterias con una actividad inhibitoria del crecimiento micelial sobre el género Fusarium. Las actinobacterias inhibieron de manera diferencial con los tres aislados de Fusarium, hongo asociado al atizonamiento en hojas indicando así una especificidad, desde un 26.3 hasta 36.4 % de inhibición en el crecimiento micelial. El uso de actinobacterias son una potencial alternativa para el control biológico de hongos patógenos de plantas, y se requiere de una extensa investigación para caracterizar la química de los compuestos de cada morfotipo y así como determinar la interacción que tienen con otras actinobacterias.











 texto em
texto em